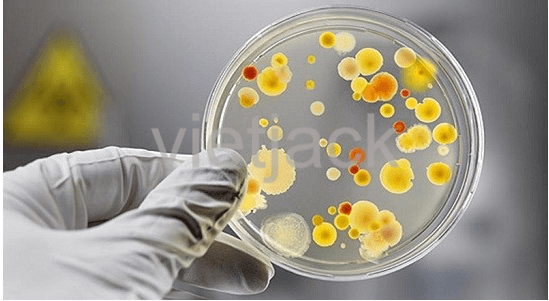
Soạn bài Sinh vật trên Trái Đất được hình thành như thế nào - Kết nối tri thức | Hay nhất Ngữ văn lớp 6

Mời quí bạn đọc tải xuống để xem đầy đủ tài liệu Soạn bài Sinh vật trên Trái Đất được hình thành như thế nào hay nhất:

Sinh vật trên Trái Đất được hình thành như thế nào
* Nội dung chính:
Văn bản nêu ra những tranh luận về quá trình hình thành Trái Đất: khí quyển, vi sinh vật, những phản ứng hóa học,…
1. Nội dung của văn bản cho em biết thêm điều gì về sự sống trên Trái Đất?
a. Khí quyển và nguồn gốc sự sống Trái Đất
– Khí quyển khi Trái Đất vừa được hình thành (cách đây 4,6 tỉ năm) bao gồm H2, NH3, CH4, H20 (hơi nước).
– Có ý kiến cho rằng khí quyển nguyên thủy có thể tạo ra những loại phân tử hữu cơ trong tế bào → Nhà hóa học Min-lơ cách đây nửa thế kỉ đã chứng minh điều đó.

– Có ý kiến khác cho rằng bụi từ sao chổi và thiên thạch gieo rắc lên hành tinh mầm mống dưới dạng vi sinh vật.
→ Vấn đề nguồn gốc vẫn được tranh luận.
b. Quy trình tạo ra sự sống trên Trái Đất
– Nước là dung môi hòa tan những phân tử, dẫn đến sự nảy nở của sự sống.
– Dưới ánh sáng Mặt Trời, khí các-bon-níc kết hợp với nước biến thành glu-cô và ô-xi. Khí ô-xi bốc lên khí quyển và duy trì sự sống trên Trái Đất. Sự hô hấp của sinh vật, sự cộng sinh giữa giới động vật và thực vật được thực hiện nhờ quy trình trên.

– Vi sinh vật sinh ra và phát triển ở những điều kiện khắc nghiệt, được nuôi dưỡng bằng những vật chất phun ra từ lòng Trái Đất. Các nhà khoa học phân vân và cho rằng sinh vật trên Trái Đất có thể xuất phát từ vi sinh vật sinh sống tận dưới đáy biển.
2. Từ mượn đã được dùng khá nhiều trong văn bản. Đó là những từ nào? Theo em từ nào trong số đó có thể được thay thế bằng một từ thuần Việt hoặc từ mượn khác quen thuộc hơn? Vì sao?
– Một số từ mượn như: hi-đrô, a-mô-ni-ắc, mê-tan, a-xít-a-min, các-bô-níc, glu-cô, ô-xi,….
– Từ glu-cô có thể thay thế bằng từ đường. Vì từ đường được sử dụng rộng rãi, phổ biến hơn từ glu-cô.
3. Sự sống được hình thành qua một quá trình dài đằng đẵng, nhưng việc hủy diệt sự sống có thể chỉ diễn ra trong chớp mắt. Điều này gợi lên trong em cảm xúc và suy nghĩ gì?
– Lo lắng cho sự sống của Trái Đất có thể bị đe dọa nghiêm trọng.
– Thấy mình cần phải có ý thức hơn trong việc bảo vệ môi trường.